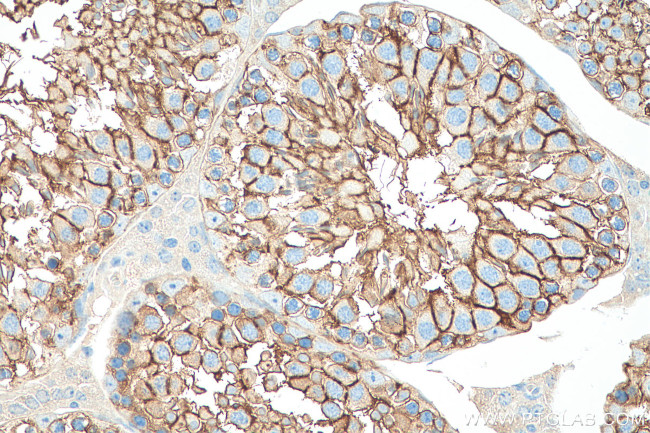
PRND Antibody in Immunohistochemistry (Paraffin) (IHC (P))

Search
Proteintech
PRND Polyclonal Antibody
{{$productOrderCtrl.translations['antibody.pdp.commerceCard.promotion.promotions']}}
{{$productOrderCtrl.translations['antibody.pdp.commerceCard.promotion.viewpromo']}}
{{$productOrderCtrl.translations['antibody.pdp.commerceCard.promotion.promocode']}}: {{promo.promoCode}} {{promo.promoTitle}} {{promo.promoDescription}}. {{$productOrderCtrl.translations['antibody.pdp.commerceCard.promotion.learnmore']}}
产品信息
26947-1-AP
种属反应
宿主/亚型
分类
类型
抗原
偶联物
形式
浓度
规格
纯化类型
保存液
内含物
保存条件
运输条件
产品详细信息
Aliquoting is unnecessary for -20°C storage.
靶标信息
This gene is found on chromosome 20, approximately 20 kbp downstream of the gene encoding cellular prion protein, to which it is biochemically and structurally similar. The protein encoded by this gene is a membrane glycosylphosphatidylinositol-anchored glycoprotein that is found predominantly in testis. Mutations in this gene may lead to neurological disorders.
仅用于科研。不用于诊断过程。未经明确授权不得转售。
生物信息学
蛋白别名: Doppelganger; downstream prion protein-like; Dpl; prion gene complex, downstream; Prion protein 2; prion protein 2 (dublet); prion protein dublet; prion protein-like protein; prion-like protein; Prion-like protein doppel; PrPLP; unnamed protein product
基因别名: AI450264; dJ1068H6.4; DOPPEL; DPL; PRND; PrPLP; UNQ1830/PRO3443
UniProt ID: (Human) Q9UKY0, (Mouse) Q9QUG3
Entrez Gene ID: (Human) 23627, (Rat) 113910, (Mouse) 26434